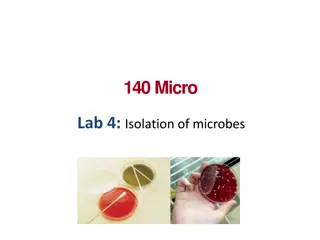

Microbial Growth: Phases and Dynamics
Microbial growth is defined as an increase in cellular constituents leading to a rise in microorganism size or population. The growth of bacterial cells is characterized by distinct phases such as lag phase and exponential phase. During the lag phase, cells are synthesizing new components before division, while the exponential phase shows rapid and consistent cell replication. The length of the lag phase varies based on surrounding conditions and inoculation factors. Understanding these growth phases is essential for studying microbial cultures.
Download Presentation

Please find below an Image/Link to download the presentation.
The content on the website is provided AS IS for your information and personal use only. It may not be sold, licensed, or shared on other websites without obtaining consent from the author.If you encounter any issues during the download, it is possible that the publisher has removed the file from their server.
You are allowed to download the files provided on this website for personal or commercial use, subject to the condition that they are used lawfully. All files are the property of their respective owners.
The content on the website is provided AS IS for your information and personal use only. It may not be sold, licensed, or shared on other websites without obtaining consent from the author.
E N D
Presentation Transcript
Microbial growth Lec.3
Microbial growth defined as an increase in cellular constituents resulting an increase in a microorganism size, population number or both.
Usually, growth of bacterial cell characterize via several changes such as total population numbers using different analysis method such as growth curve of microbial culture. When M.O are cultivated in liquid medium, they are grown in a batch culture or closed system ,because no fresh medium is provided concentrations decline and concentrations of wastes are increased. The growth of microorganisms reproducing by binary fission can be plotted as the logarithm of the number of viable cells versus the incubation time, resulting in curve has four distinct phases. during incubation, nutrient
1-Lag phase When M.O are inoculated into fresh culture medium, will not reproduce immediately, therefore this period is called the lag phase.
During the lag phase bacterial cell will not divide into new cells in addition there is no net increase in mass, however the cell is synthesizing new components. A lag phase considers a vital period prior to cell division because of the age of the cell, depleted of ATP molecules, essential cofactors and ribosomes. Which must be synthesized before growth can begin.
The surrounding medium different from the original where the M.O used to grow previously, new enzyme for different nutrient molecules could involve for consumption different nutrients. After all the previous stages cells begin to replicate their DNA, increase in cell mass and finally divide into two new daughter.
The lag phase varies in length depending on the surrounding conditions, it may be long if the inoculums is from an old culture or one that has been refrigerated. Inoculation of a chemically different medium also results in a longer lag phase, while fresh exponential phase culture when inoculated into a new batch could reduce the length of lag phase which would be short or absent.
Exponential (log) phase Microorganisms logarithmatic order at maximal rate. During the log phase the M.O are growing under constant conditions including (nutrient and division rate) causing a uniform identical new cells at regular intervals. start replicate their number in
The population is most uniform in chemical & physiological characteristic therefore exponential phase cells employing in biochemical and physiological studies. Exponential growth is stable therefore, cellular constituents are manufactured at constant rates relatives to each other. The reduction of nutrient levels and O2 variation in environmental conditions resulting in slowing the growth.
3-Stationary phase In the stationary phase the total number of viable microorganisms remains constant, this may result from a balance between cell division & cell death, or the population may simply cease to divide though remaining metabolically active. Microbial population enter the stationary phase for several reasons; nutrient limitation, if an essential nutrient is severely depleted, population growth will slow.
Population size depends on nutrient availability & other factors, as well as the type of M.O being cultured. Aerobic organisms are limited by O2 availability, because O2 resulting depleted quickly therefore only the surface of batch culture continue to grow due to presence of the appropriate level of O2. The cells beneath the surface will not be able to grow unless the culture is shaken or aerated in another way. Growth also may cease due to the accumulation of toxic waste products
Bacteria in a batch culture may enter stationary phase in response to starvation, this occurs in nature environment when nutrient levels are low.
Death phase Decline in the number of viable cells result from unsuitable conditions, the death of microbial population may be logarithmic like it s growth during the log phase, the total cell number remains constant because the cells fail to lyse after dying, only way of deciding whether a bacterial cell is viable is by incubating it in fresh medium, if it does not grow and reproduce, it is assumed to be dead. Death is defined to be the irreversible loss of the ability to reproduce.
Generation time During the exponential phase each M.O is dividing at constant intervals, thus the population will double in number during a specific length of time called the generation time or doubling time, g.t vary with the species of M.O and environmental conditions, it range from less than 10 minutes for several days g.t in nature is much longer than in culture .
Measurement of microbial growth can be determined by: 1- Measurement of cell numbers 2- Measurement of cell mass Types of culture systems 1.Batch cultures or closed system: In which nutrient supplies are not renewed nor wastes removed, exponential growth lasts for only a few generations and soon the stationary phase is reached.
1.Continuous Microorganisms are growing in a system with constant environmental through continual provision of nutrients & removal of wastes, these conditions are met in the lab. By a continuous culture system. culture system (open system): conditions maintained
A microbial population can be maintained in the exponential growth phase and at a constant biomass concentration for extended periods in a continuous culture systems, these systems are very useful because they provide a constant supply of cells in exponential phase and growing at a known rate, they make possible the study of microbial growth at very low nutrient levels, these systems are essential
for research; in studies on interactions between microbial species under certain environmental conditions, they also used in food & industrial microbiology.
Figure: Microbial growth curve in a closed system note the 4 phases
References References 1. Microbial Physiology. Albert G Moat, John W Foster, Michael P. Spector. 2002. Fourth Edition. A John Wiley and sons, INC., publication. 2. Microbiology. Lansing M Prescott, John P. Harley, Donald A. Klein.2004. Sixth Edition. Higher Education. 3. Microbial an introduction. 2004. Gerard J Tortora, Berdell R Funke, Christine L Case. Eighth Edition.